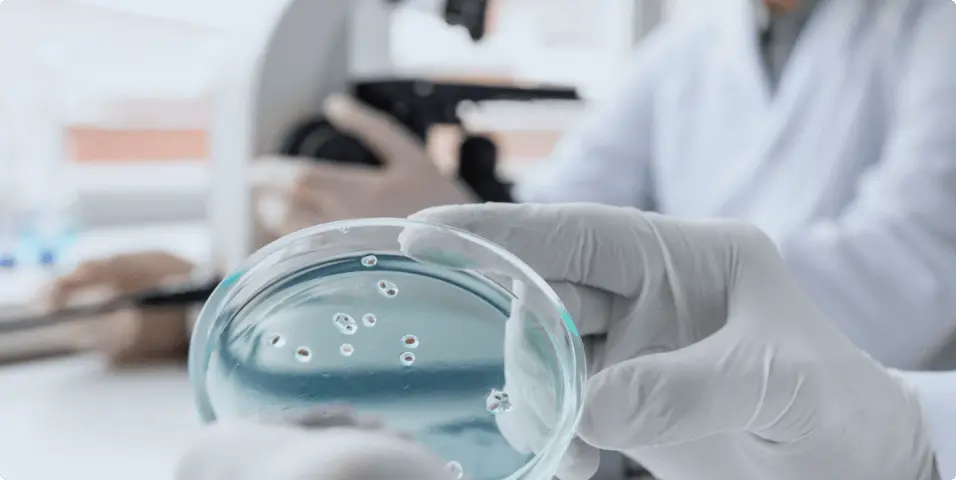

رواد في ابتكار الرعاية الصحية النباتية
مركز الابتكار للعلاجات الطبيعية
3 عقود من ابتكار البحث والتطوير
على مدار العقود الثلاثة الماضية، نجحنا في تطوير وإطلاق مجموعة واسعة من منتجات الرعاية الصحية الطبيعية المبتكرة. تُستخدم منتجاتنا لحماية وشفاء ملايين الحيوانات حول العالم.
يعد مركز الابتكار للعلاجات الطبيعية منصة متطورة لتطوير منتجات الرعاية الصحية الطبيعية المبتكرة، حيث يلبي احتياجات التغذية والرعاية الصحية للإنسان والحيوان على حد سواء. وباعتبارنا رواداً معترفاً بهم في مجال الأعشاب والمركبات النباتية، فإننا نستخدم أحدث التقنيات لابتكار حلول جديدة لتحسين فعالية المنتجات وزيادة الربحية.
يمتد مركز البحث والتطوير لدينا على مساحة 25,000 قدم مربع، ويوظف أكثر من مائة عالم من تخصصات متعددة يقومون بإجراء دراسات ما قبل السريرية متنوعة.
كما أن قسم الكيمياء التحليلية لدينا هو أيضاً مختبر اختبار عام معتمد من الحكومة لتحليل مكونات الأيورفيدا والسيدها واليوناني، وعلم الأحياء الدقيقة والتركيبات النهائية.
علم صحة الحيوان
تعد العلاجات الطبيعية واحدة من الشركات القليلة للرعاية الصحية الحيوانية العشبية في الهند التي لديها قسم مخصص لعلوم صحة الحيوان. يقود هذا القسم أطباء بيطريون مؤهلون وعلماء ذوو خبرة يجرون تجارب سريرية وميدانية بيطرية على الأنواع المستهدفة. كما تُجرى تجارب على الدواجن والماشية والأغنام والماعز والخنازير والجمبري لفهم المزيد عن مكيفات الجسم، والبدائل للمغذيات الاصطناعية، وأمراض الجهاز التنفسي في الدواجن، والإجهاد الحراري في الدواجن، وجروح الحيوانات بالتعاون مع المزارعين والمعاهد (المحلية والدولية) لتقييم قابلية ترجمة النتائج إلى الميدان في ظل الظروف الزراعية المناخية المتغيرة.
مجالات الخبرة
تصور وتصميم التجارب وإجراء وتنفيذ التجارب في الدواجن والحيوانات الميدانية للماشية والخنازير والأغنام والماعز والجمبري. الهدف الرئيسي هو فحص وتوليد بيانات الفعالية والسلامة لمنتجاتنا العشبية وفقًا لإرشادات VICH. الدراسات المتعلقة بمكيفات الجسم، وتعديل المناعة، ووظائف الأمعاء، وتأثير محاكاة الكولين، وتعزيز النمو، وتحسين إنتاج البيض، والتئام الجروح، والوظيفة التناسلية هي بعض مجالات تخصصنا. قدم مركز البحث والتطوير لدينا للعالم منتجات مبتكرة مثل مكيف الأمعاء للدواجن، ومكيف الأمعاء العشبي للخنازير، وعلاج التهاب اللفائفي في الخنازير والكولين الطبيعي للدواجن على سبيل المثال لا الحصر.
على الرغم من أننا في العلاجات الطبيعية حريصون على فعل المزيد، إلا أن التحديات واسعة. ولمواجهة هذه التحديات، بنينا علاقات قوية مع مزارعينا الهنود، والأطباء البيطريين الميدانيين، والمعاهد، والجامعات لإجراء التجارب السريرية والميدانية البيطرية أيضًا.
مجالات الخبرة
الكيمياء النباتية
- تحديد الأدوية الخام باستخدام تقنيات علم العقاقير.
- عزل العلامات لتوحيد المنتجات العشبية.
- التجزئة الموجهة بيولوجياً للأعشاب لعزل مركباتها النشطة بيولوجياً.
- تطوير إجراءات الاستخلاص للنباتات الطبية.
- عزل المركبات الكيميائية النباتية عالية النقاء للاستخدام كمعايير مرجعية للتحليل الكروماتوغرافي.
الكيمياء النباتية
- تحديد الأدوية الخام باستخدام تقنيات علم العقاقير.
- عزل العلامات لتوحيد المنتجات العشبية.
- التجزئة الموجهة بيولوجياً للأعشاب لعزل مركباتها النشطة بيولوجياً.
- تطوير إجراءات الاستخلاص للنباتات الطبية.
- عزل المركبات الكيميائية النباتية عالية النقاء للاستخدام كمعايير مرجعية للتحليل الكروماتوغرافي.

المقايسة البيولوجية
- تطوير طرق دوائية في المختبر لتقييم الأدوية.
- التوحيد البيولوجي للمنتجات العشبية.
- تطبيق طرق المقايسة البيولوجية لاختبار الثبات واختبار التأثير التركيبي للمستخلصات العشبية.
المقايسة البيولوجية
- تطوير طرق دوائية في المختبر لتقييم الأدوية.
- التوحيد البيولوجي للمنتجات العشبية.
- تطبيق طرق المقايسة البيولوجية لاختبار الثبات واختبار التأثير التركيبي للمستخلصات العشبية.

علم الأحياء الدقيقة
- تحليل المنتجات العشبية للتلوث الميكروبيولوجي.
- تحديد الحد الأدنى للتركيز المثبط (MIC).
- التصوير الحيوي بالغمر لتحديد المركبات المضادة للبكتيريا.
- اختبار فعالية المواد الحافظة.
- تطوير أنظمة المواد الحافظة.
- اختبار مستخلصات النباتات ومشتقاتها للتأثيرات التركيبية لتحديد التآزر والتضاد والإضافة.
علم الأحياء الدقيقة
- تحليل المنتجات العشبية للتلوث الميكروبيولوجي.
- تحديد الحد الأدنى للتركيز المثبط (MIC).
- التصوير الحيوي بالغمر لتحديد المركبات المضادة للبكتيريا.
- اختبار فعالية المواد الحافظة.
- تطوير أنظمة المواد الحافظة.
- اختبار مستخلصات النباتات ومشتقاتها للتأثيرات التركيبية لتحديد التآزر والتضاد والإضافة.
علم الزراعة
- القيام بالزراعة التعاقدية لنباتات طبية هندية مختارة من خلال المزارعين المهتمين وتقديم عرض إعادة شراء بنسبة 100٪.
- توفير مواد الزراعة وخطة الزراعة الكاملة للمزارعين والإشراف على التنفيذ الصحيح للخطة.
- الاختيار والتحديد المناسب، وطرق التكاثر، وتقنيات الزراعة، والحصاد، ومراقبة الجودة خطوة بخطوة للمواد الخام حتى مرحلة المعالجة، والمعالجة بعد الحصاد، والتخزين والسلامة.
علم الزراعة
- القيام بالزراعة التعاقدية لنباتات طبية هندية مختارة من خلال المزارعين المهتمين وتقديم عرض إعادة شراء بنسبة 100٪.
- توفير مواد الزراعة وخطة الزراعة الكاملة للمزارعين والإشراف على التنفيذ الصحيح للخطة.
- الاختيار والتحديد المناسب، وطرق التكاثر، وتقنيات الزراعة، والحصاد، ومراقبة الجودة خطوة بخطوة للمواد الخام حتى مرحلة المعالجة، والمعالجة بعد الحصاد، والتخزين والسلامة.

الكيمياء التحليلية والأجهزة
- تطوير معايير تقييم الجودة ذات المغزى للنباتات التي لا تُعرف مكوناتها النشطة/النشطة بيولوجياً.
- التحديد الكمي للمبادئ النشطة المعروفة، والعلامات الحيوية، والمكونات المميزة في المواد الخام، والمستخلصات، والزيوت الأساسية باستخدام HPLC، HPTLC، GC وغيرها.
- تطوير والتحقق من صحة الإجراءات التحليلية.
- تحليل المتبقيات (المعادن الثقيلة، السموم الفطرية، المبيدات والمذيبات).
- اختبار الثبات.
- توحيد المنتجات العشبية.
الكيمياء التحليلية والأجهزة
- تطوير معايير تقييم الجودة ذات المغزى للنباتات التي لا تُعرف مكوناتها النشطة/النشطة بيولوجياً.
- التحديد الكمي للمبادئ النشطة المعروفة، والعلامات الحيوية، والمكونات المميزة في المواد الخام، والمستخلصات، والزيوت الأساسية باستخدام HPLC، HPTLC، GC وغيرها.
- تطوير والتحقق من صحة الإجراءات التحليلية.
- تحليل المتبقيات (المعادن الثقيلة، السموم الفطرية، المبيدات والمذيبات).
- اختبار الثبات.
- توحيد المنتجات العشبية.

التركيب والتطوير
- تطوير معايير تقييم الجودة ذات المغزى للنباتات التي لا تُعرف مكوناتها النشطة/النشطة بيولوجياً.
- التحديد الكمي للمبادئ النشطة المعروفة، والعلامات الحيوية، والمكونات المميزة في المواد الخام، والمستخلصات، والزيوت الأساسية باستخدام HPLC، HPTLC، GC وغيرها.
- تطوير والتحقق من صحة الإجراءات التحليلية.
- تحليل المتبقيات (المعادن الثقيلة، السموم الفطرية، المبيدات والمذيبات).
- اختبار الثبات.
- توحيد المنتجات العشبية.
التركيب والتطوير
- تطوير معايير تقييم الجودة ذات المغزى للنباتات التي لا تُعرف مكوناتها النشطة/النشطة بيولوجياً.
- التحديد الكمي للمبادئ النشطة المعروفة، والعلامات الحيوية، والمكونات المميزة في المواد الخام، والمستخلصات، والزيوت الأساسية باستخدام HPLC، HPTLC، GC وغيرها.
- تطوير والتحقق من صحة الإجراءات التحليلية.
- تحليل المتبقيات (المعادن الثقيلة، السموم الفطرية، المبيدات والمذيبات).
- اختبار الثبات.
- توحيد المنتجات العشبية.

علم الأدوية والسموم
- نماذج المناعة.
- نماذج الالتهاب.
- نماذج حماية الكبد.
- نماذج شفاء الجروح.
- نماذج الإسهال.
- نماذج التكيف.
- نماذج الإجهاد.
- نماذج الإجهاد التأكسدي.
- نماذج الاضطرابات الأيضية.
علم الأدوية والسموم
- نماذج المناعة.
- نماذج الالتهاب.
- نماذج حماية الكبد.
- نماذج شفاء الجروح.
- نماذج الإسهال.
- نماذج التكيف.
- نماذج الإجهاد.
- نماذج الإجهاد التأكسدي.
- نماذج الاضطرابات الأيضية.

الفحوصات الخلوية
- فحوصات المناعة (فحص تكاثر الخلايا الليمفاوية؛ البلعمة بواسطة البلاعم الكبيرة؛ فحص إطلاق السيتوكين وغيرها).
- فحوصات الالتهاب (إزالة أكسيد النيتريك؛ فحوصات إطلاق الوسطاء مثل Il-1beta وIL-6 وPGE2 وغيرها).
- فحوصات الإجهاد (فحص إطلاق الكورتيزول؛ فحص مضاد CRHR1).
- فحوصات مضادات الأكسدة.
- فحوصات شفاء الجروح.
الفحوصات الخلوية
- فحوصات المناعة (فحص تكاثر الخلايا الليمفاوية؛ البلعمة بواسطة البلاعم الكبيرة؛ فحص إطلاق السيتوكين وغيرها).
- فحوصات الالتهاب (إزالة أكسيد النيتريك؛ فحوصات إطلاق الوسطاء مثل Il-1beta وIL-6 وPGE2 وغيرها).
- فحوصات الإجهاد (فحص إطلاق الكورتيزول؛ فحص مضاد CRHR1).
- فحوصات مضادات الأكسدة.
- فحوصات شفاء الجروح.










